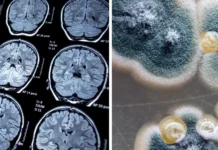
Mould, Bacteria And Alzheimers Mould and Alzheimers
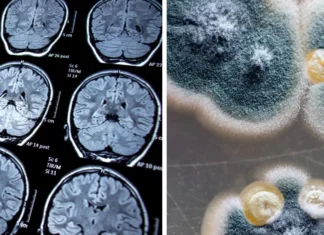
Mould, Bacteria And Alzheimers Mould and Alzheimers

Got unexplained rashes that just won’t budge? Mould exposure could be the culprit. This category explores the connection between indoor air quality and skin problems in Aussies. We’ll discuss how mould spores and irritants can trigger rashes, itching, and other skin issues. Learn how to identify mould problems in your home and create a healthier environment to soothe your skin and improve your overall well-being. We’ll also provide tips on recognizing the difference between mould-related rashes and other skin conditions, and emphasize consulting a doctor for diagnosis and treatment.
Home Health Related Symptoms Symptoms of Mould and Bacterial Exposure Mould, Bacteria And Skin Irritation